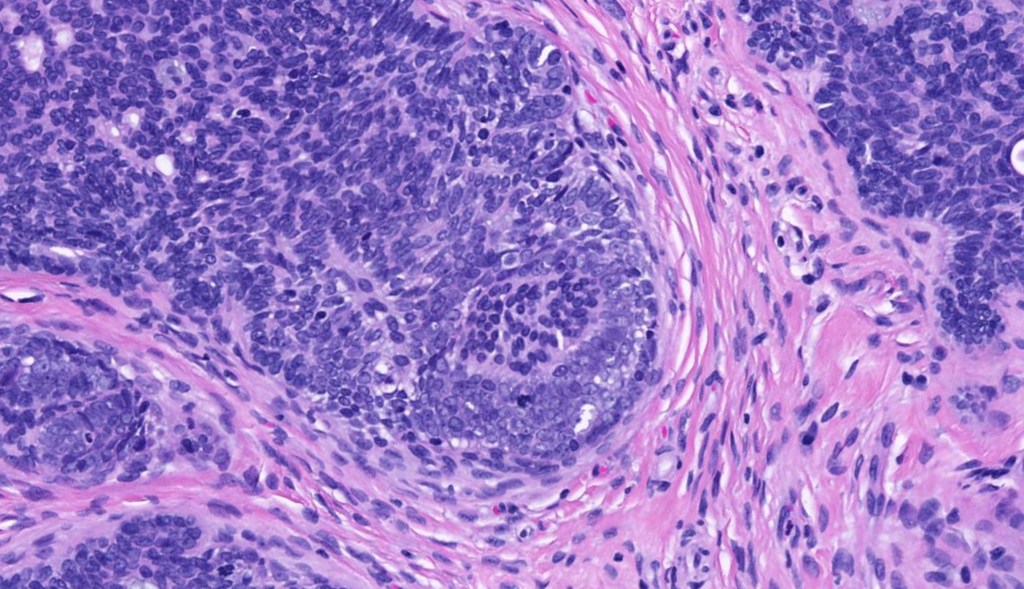

Trichoepithelioma is a hamartoma comprising a basaloid/germinative component and a prominent perifolliclular sheath proliferation. It may present as a solitary lesion or as multiple, familial lesions in multiple familial trichoepithelioma (which is probably a variant of Brook-Spiegler syndrome) & Brook-Spiegler syndrome.
Clinical features
•Solitary trichoepithelioma presents as a flesh-colored papule or nodule (<1.0 cm) most often on the face.
•Lesions may occasionally be seen at other sites including the scalp, neck, back, vulva & proximal extremities
•Multiple familial trichoepithelioma maps to 16q12-q13 mutations (CYLD)
•Multiple familial trichoepithelioma (epithelioma adenoides cysticum) is an autosomal dominant condition with diminished expression in males.
•Presents with symmetrically distributed numerous skin-colored papules on the naso-labial folds, eyebrows, eyelids & cheeks
•Generally, not associated with systemic disease
•Brooke-Spiegler syndrome also maps to 16q12-13 (tumor suppressor gene CYLD) (familial cylindromatosis, turban tumor syndrome) and comprises multiple cylindromas, spiradenomas, multiple trichoepitheliomas & milia.
•Patients can present with multiple trichoepitheliomas or cylindromas or both ( there is considerable overlap with multiple familial trichoepitheliomas. Indeed, this may represent one end of the spectrum)
•Hybrid tumors are sometimes seen (spiradenocylindromas)
•Patients may also develop trichoblastoma as well as parotid gland lesions
•Late complications include malignant change- carcinoma ex cylindroma/ spiradenoma, high grade trichoblastic carcinoma & carcinosarcoma
•Rombo syndrome, an autosomal dominant condition comprises multiple trichoepitheliomas, milia, vermiculate atrophy, basal cell carcinoma, vellus hair cysts, peripheral vasodilatation & cyanosis





Histological features
•The classical appearance consists of keratocysts & lobules of basaloid cells
•Some tumors are devoid of keratocysts
•Variable continuity with the epidermis
•Basaloid lobules show peripheral palisading
•Retraction artifact and mucin deposition as seen in BCC are not present
•Mitoses & apoptosis may be present
•Perifollicular mesenchyme is always conspicuous and sometimes densely aggregated are seen indenting the baslaloid lobules (papillary mesenchymal bodies)
•Narrow epithelial strands arising from the basaloid lobules are often present
•Amyloid, foreign body granuloma formation to free keratin & calcification are variable features

Differential diagnosis
Trichoepithelioma should be distinguished from trichoblastoma since the latter is very rarely syndromic. Trichoepithelioma is largely a dermal tumor whereas trichoblastoma often extends from the dermis into subcutaneous fat or deeper in very large examples. Papillary mesenchymal bodies are much better formed and generally more obvious in trichoepithelioma. Trichoepithelioma must also be distinguished from basal cell carcinoma. Retraction artifact & stromal mucin are features of basal cell carcinoma and not trichoepithelioma. Papillary mesenchymal bodies are not seen in basal cell carcinoma.
Although the immunohistochemical findings are not always clear cut, points of disctintion are shown in the table.

Leave a comment